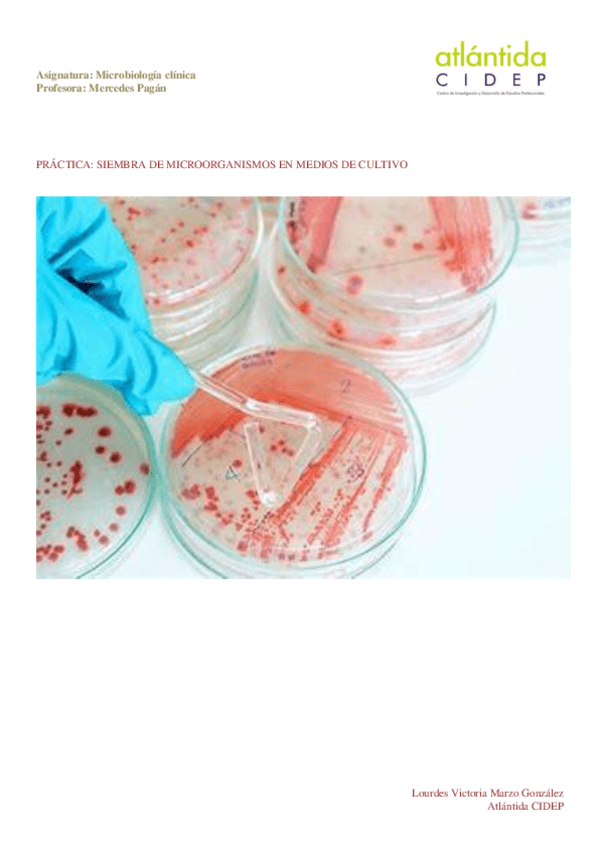
Miniatura del documento SIEMBRA-DE-MICROORGANISMOS.pdf

SIEMBRA-DE-MICROORGANISMOS.pdf

Portada

Asignatura
account_balance
Laboratorio Clínico y Biomédico
Fecha de subida
05 mar 2024
Categoría
practicas
Etiquetas
content_copy

Portada
Asignatura
Laboratorio Clínico y Biomédico
Fecha de subida
05 mar 2024
Categoría
practicas
Etiquetas